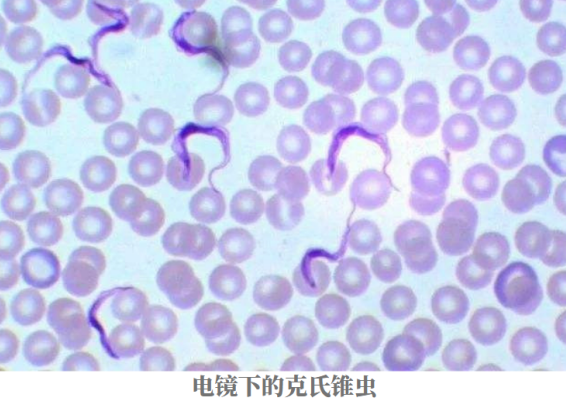

IgG檢測技術在克氏錐蟲和查加斯病抗體檢測的應用

查加斯病:
查加斯病是最為普遍的“被忽視的熱帶病”之一。因其病例多分布于于中美洲和南美洲,并主要在拉丁美洲的農村流行,因此,查加斯病也曾被命名為美洲錐蟲病。據世衛組織估計,全球目前約有 1000 萬人感染克氏錐蟲,高危人群多達2500多萬。
查加期病患者一旦疾病進入慢病期就很難臨床治愈,將對患者造成嚴重的負擔,因此,早確診早治療是臨床治愈查加斯病的關鍵。
查加斯病的傳播途途徑:
查加斯病的致病原——克氏錐蟲,寄生于吸血昆蟲錐蝽體內。有130余種錐蝽可攜帶克氏錐蟲。錐蝽在我國主要分布于廣東和海南等地,其中紅帶錐蝽在我國華南地區較為常見。我們曾發現過輸入性的查加斯病的病例,且于 2017 年在廣東佛山已證實紅帶錐蝽的存在,因此,我國查加斯病流行的風險不可忽視。

除了蟲媒傳播,不慎食用被錐蟲污染的食物、接觸被感染動物排泄物、輸入感染者的血液都可能被感染。此外,當孕婦感染克氏錐蟲,不管孕婦有無癥狀,都可能傳播給胎兒。

查加斯病什么癥狀?
被克氏錐蟲叮咬后的1-2周內,少數人會出現紅斑和硬結(查加斯結節)、發熱、頭痛、食欲不振、乏力、腹瀉、惡心、嘔吐、呼吸困難等癥狀。極少數人會因并發急性心肌炎導致急性心衰或急性腦膜炎,而導致死亡。
多數成年人在感染克錐氏蟲后是無癥狀患者,這增加了查加斯病及早發現的難度,成為查加斯病社區流行的高風險因素。
克氏錐蟲感染急性期后進入隱匿期,約50%-70%的患者進入隱匿期即不再發病。約有三分之一的患者發展為慢性美洲錐蟲病,出現與心臟、食管、結腸和神經系統等相關的癥狀,并持續終生。
查加斯病怎么檢查?
克氏錐蟲的診斷試驗包括顯微鏡檢查、病原分離、血清學試驗或分子生物學技術。人體最初感染克氏錐蟲后,會產生高水平的IgM抗體、IgG抗體持續升高。急性期后,IgG抗體達到最高水平,并持續終生。在慢性期,常用血清學方法檢測特異性IgG抗體,ELISA和間接免疫熒光試驗和間接血凝試驗是最常用的方法。3種常規方法中,如有2種為陽性,即可確診。
德國IBL公司的RE58691查加斯(克氏錐蟲)IgG檢測試劑盒(ELISA法),可用于人血清或血漿中抗克氏錐蟲IgG抗體的定性檢測,在國內抗錐蟲流行的過程中發揮過重要作用。

結語
由于錐蝽叮咬人時不會帶來強烈的疼痛感,且多在夜間活動,這使克氏錐蟲潛入人體時不易被察覺,而多數人感染克氏錐蟲后無明顯癥狀也增加了流行的風險。同時,查加斯病目前尚無疫苗,因此,識別并預防錐蝽叮咬,及時檢查可疑病例,是預防查加期病社區流行的重要手段。科潤達生物作為IBL的中國代理和技術服務單位,可以為廣大用戶穩定提供試劑盒,并提供收樣代測,上門實驗指導服務。我們歡迎您拔打400-9600529咨詢,無論您親自下單還是咨詢技術問題,我們將真誠服務!
Copyright(C) 1998-2025 生物器材網 電話:021-64166852;13621656896 E-mail:info@bio-equip.com






